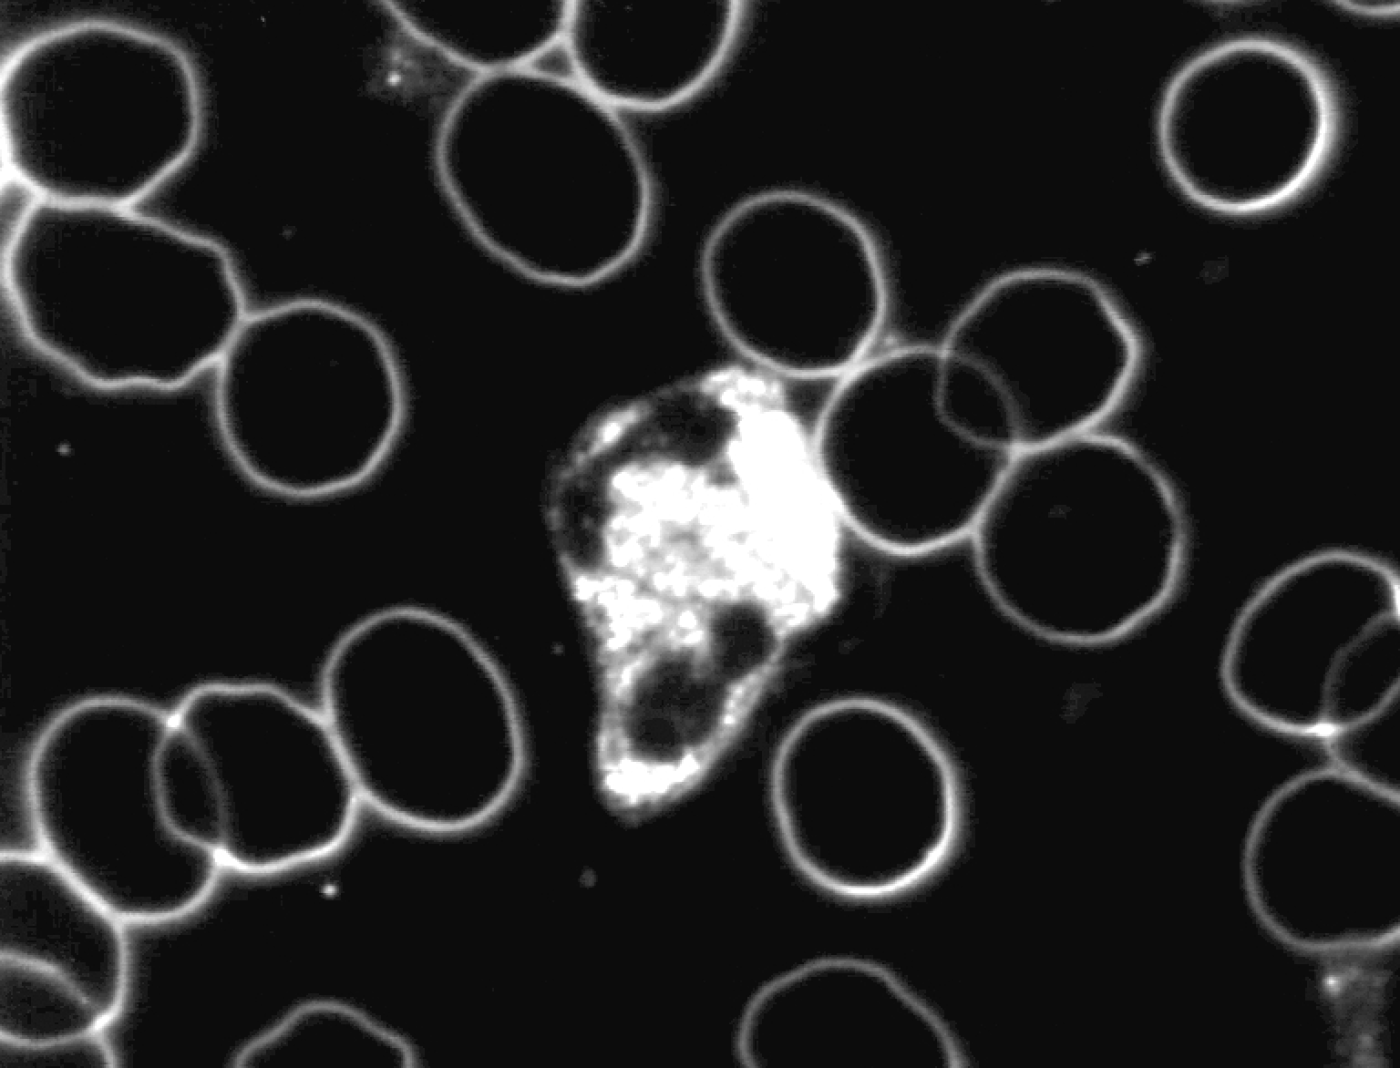
20_actief.jpg

Levend bloedanalyse
Een verslag van een experiment, waarbij de effecten van Ozaliet, de voorloper van de Vitalisatie Verbinding en Benzoliet, de voorloper van de Neutralisatie Verbindingen, zichtbaar werden gemaakt met behulp van levend bloedanalyse uitgevoerd door M. Klatte, arts.
Onderzoeksvraagstelling
Treden er veranderingen op in het levend bloedbeeld die er op wijzen dat de effectiviteit van het immuunsysteem van een proefpersoon vermindert door blootstelling aan verschillende verstorende subtiele energieën.
Indien dit het geval is, zijn Ozaliet en Benzoliet dan in staat door neutralisatie van de toegepaste verstorende subtiele energieën het levend bloedbeeld weer te corrigeren.
Karakteristiek van Ozaliet en Benzoliet
Ozaliet en Benzoliet zijn producten gebaseerd op zeezout, waaraan energiefrequenties zijn toegevoegd met het doel om verstorende subtiele energieën te neutraliseren.
Deze verstorende subtiele energieën die o.a. afkomstig zijn van elektra, gas, leidingwater, radar, radio- en televisiezendstraling, geopathie, etc verstoren de werking van de aura van mens, dier en plant.
Omdat de aura de blauwdruk (het ontwerp) van ons lichaam is, heeft dit veel ingrijpender gevolgen dan men over het algemeen veronderstelt.
Benzoliet is met name afgestemd op het neutraliseren van de technische en geopathische verstorende subtiele energieën, terwijl de energiefrequenties in Ozaliet zijn afgestemd op het weer opbouwen van een verstoorde en daardoor verkleinde aura.
Daarnaast kunnen m.b.v. Ozaliet een aantal verstorende subtiele energieën zoals die, afkomstig van voedingsmiddelen, chemische producten, medicijnen etc. worden geneutraliseerd.
Proefopzet
Voor de proef is een opstelling gemaakt met een donker veldmicroscoop (vergroting 4000 x). Deze microscoop is verbonden met een videocamera die het microscopisch beeld op een monitor weergeeft.
Er wordt een druppel bloed afgenomen uit de vingertop van een gezonde proefpersoon.
De proef bestaat uit het waarnemen van het microscopisch beeld van dezelfde druppel levend bloed, terwijl de omstandigheden van de proefpersoon telkens worden gewijzigd in proef 1 en 2. Voor proef 3 is opnieuw bloed afgenomen. Tevens zijn de beelden op video opgenomen.
Bij elke verandering van omstandigheid werd het bloedbeeld gedurende ongeveer 20 minuten door 4 waarnemers bestudeerd. Slechts de geconstateerde veranderingen in het levend bloedbeeld, waarover consensus bestond, zijn genoteerd.
Tevens werd direct nadat de proefomstandigheid van de proefpersoon was veranderd en voordat de veranderingen in het levend bloedbeeld zichtbaar werden m.b.v. wichelroeden de straal van de aura van de proefpersoon gemeten.
Proef 1 Invloed van technische en geopathische verstorende energieën
Voor deze proef werden elektra, gas en een zware aardstraal in het huis waar de analyse werd uitgevoerd, geneutraliseerd met het Benzoliet.
De neutralisatie van de verstorende subtiele energieën van de elektra vond plaats door per 4 groepen (stoppen) een verpakking Benzoliet a 200 g op de elektriciteitsmeter te leggen.
De verstorende subtiele energieën van het gas en daarmee van de CV radiatoren werden geneutraliseerd door een verpakking Benzoliet op de gasmeter te leggen.
De aardstraal werd met behulp van de wichelroeden opgespoord en vervolgens met 3 verpakkingen Benzoliet geneutraliseerd.
Waargenomen veranderingen:
Na de neutralisatie vertonen de witte bloedlichaampjes (granulocyten) een verhoogde motiliteit en de intracellulaire activiteit neemt toe. De vorming van pseudopodieën treedt frequenter op. De witte bloedlichaampjes kunnen dan actief zijn in het afweersysteem.
Zie ook onderstaande foto’s met een karakteristiek beeld van vóór en na de neutralisatie met Benzoliet.

Levend bloedbeeld
vóór neutralisatie met Benzoliet
Levend bloedbeeld
na neutralisatie met Benzoliet
Proef 2 Invloed van Ozaliet inname
Voor deze proef heeft de proefpersoon 2 gram Ozaliet in een beker water ingenomen.
Waargenomen veranderingen:
De witte bloedlichaampjes worden over een periode van een half uur steeds actiever totdat ze als super actief geclassificeerd kunnen worden. Deze verhoogde activiteit gaat gepaard met een verhoogde motiliteit, veelvormigheid en een verhoogde intracellulaire activiteit.
Daarnaast worden in eerste instantie de witte cellen en later ook de rode cellen steeds blauwer van kleur.
De aura van de proefpersoon groeit 5 minuten na inname naar een straal van +/- 4 meter, 18 minuten na inname naar een straal van +/- 5 meter en 35 minuten na inname naar een straal van +/- 7 meter.
Proef 3 Bloedbeeld na het nemen van een nieuwe druppel bloed
37 Minuten na inname van 2 gram Ozaliet wordt een nieuwe bloeddruppel afgenomen en onder de microscoop gebracht.
Na 10 minuten vertoont een witte cel van deze nieuwe bloeddruppel dezelfde aktiviteit als de witte cellen in de eerste bloeddruppel. Ook de blauwe kleur van witte en rode cellen heeft dezelfde intensiteit als in proef 2.
Samenvatting en conclusies
Het levend bloedbeeld veranderde in proef 1 en 2 mee met de proefomstandigheden van de proefpersoon. Dit geeft een onderbouwing van de veel gehoorde hypothese dat het deel het geheel vertegenwoordigt.
Het bloedbeeld in proef 3, waarbij opnieuw bloed was afgenomen, stemde in hoge mate overeen met het bloedbeeld in proef 2. Dit geeft een bevestiging, dat de veranderingen in een druppeltje bloed onder invloed van de inwerking van omgevingsfactoren identiek zijn aan de veranderingen van het bloed zoals deze optreden in het lichaam van een proefpersoon.
Uit deze levend bloedanalyses blijkt, dat subtiele verstorende energieën van verschillende bronnen afkomstig, het bloedbeeld beïnvloeden.
De veranderingen die we hebben geconstateerd in met name de witte cellen na blootstelling aan technische en geopathische verstorende subtiele energieën, waren:
- afname van beweeglijkheid van de cel
- het aannemen van de bolvorm
- afgenomen en op een plek geconcentreerde cytoplasmatische activiteit
Onze conclusie is dat de effectiviteit van het immuunsysteem onder invloed van de subtiele verstorende energieën vermindert.
De veranderingen die werden geconstateerd na neutralisatie van de toegepaste verstorende subtiele energieën door Benzoliet in met name de witte cellen waren:
- toegenomen mobiliteit
- toegenomen en homogeen over de cel verspreide cytoplasmatische activiteit
- verlaten van de bolvorm
- het vormen van pseudopodieën
Hieruit volgt de conclusie dat Benzoliet in staat is de in de proef toegepaste verstorende subtiele energieën te neutraliseren en dat door neutralisatie het afweersysteem beter kan functioneren.
Door het innemen van Ozaliet intensiveren alle veranderingen, die reeds waren geconstateerd na neutralisatie van de subtiele verstorende energieën door Benzoliet.
Opvallend is dat de straal van de aura zoals door Bas met de wichelroede gemeten, synchroon liep met de kwaliteit van het levend bloedbeeld.
Bas van Woelderen
februari 1996

